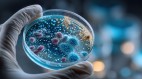
病毒捕食者浮游纤毛虫(图)

- 从天而降的意外 车内被它塞满“榛果”(图)
- 来自印度的英国神秘动物 活了至少79年(图)
- 病毒捕食者 浮游纤毛虫(图)
- FBI调查揭密 沙斯塔山是大脚怪出没的场所(图)
- 活恐龙目击事件?智利沙漠中的阿里卡怪兽(图)
- 康沃尔郡奇遇 桌上的小矮人不是雕像(图)
- 传说不是虚构 雷鸟的真实目击事件(图)
- 熊湖怪兽是“水怪”?一百多年间多次目击(图)
- 加拿大午夜惊魂 与“狼人”短兵相接(图)
- 目击事件数以百计 居民却不怕的“弗拉特黑德湖怪兽”(图)
- 探险遭遇超自然 肯塔基采石场的大脚怪(图)
- 随着洪水出没 多人目击“洪水妖精”(图)
- 矮小的自然守护者 亚平宁山脉中有小矮人(图)
- 索命的报应 带来预知的神秘酪梨树与橘子树(图)
- 英美都出现?猫头鹰人的目击事件(图)
- 迷信山惊魂 沙漠中的“光人”(图)
- 森林步道中的异味与恐惧 众人看见黑色幽灵(图)
- 一次丛林武装行动 18人遇上自己的“复制人”(图)
- 动物有灵性 拯救人类的真实故事(图)
- 收到心灵感应?深夜公路休息区遭遇非人生物(图)
- 将近3米的“怪物”糖面包山的骷髅(图)
- 违反“她”的规则将付出生命 鹿夫人(图)
- 已经灭绝?只能从罕见标本上认识的3种鸟类(图)
- 大脚怪多次出没各地 猎人目击“金刚”出现(图)
- 阿根廷UFO高速公路 有工人遭隐形人袭击(图)
- 海底的摩斯密码 神秘的“咔哒”声(图)
- 大象的智慧超乎想像 每只都有属于自己的名字(图)
- 南美洲的千年壁画 国家保护区内捕捉巨蛇(图)
- 金德胡克斑点怪兽的传说 幽灵般的生物(图)
- 大学生触怒森林精灵 树屋彻底崩塌(图)
- 森林奇遇 变成鹿的男生(图)
- 森林少女与银色光球 人类与精灵的邂逅(图)
- 深海发现“暗氧”开采将导致第六次物种大灭绝?(图)
- 艾琳多南岛上的传说 水獭王与海豹精(图)
- 地下室的幽灵猫 房东留下的幽灵狗(图)
- 横跨欧美 小矮人们的现代目击事件(图)
- 童年宠物猫的转世?地下室出现蓝色光影(图)
- 只需半个月 它失去的眼睛就能完全“再生”(图)
- 洪都拉斯的精灵 治愈视力恶化的草药师(图)
- 熊兄弟的传说 山中老人与转世的奇闻(图)